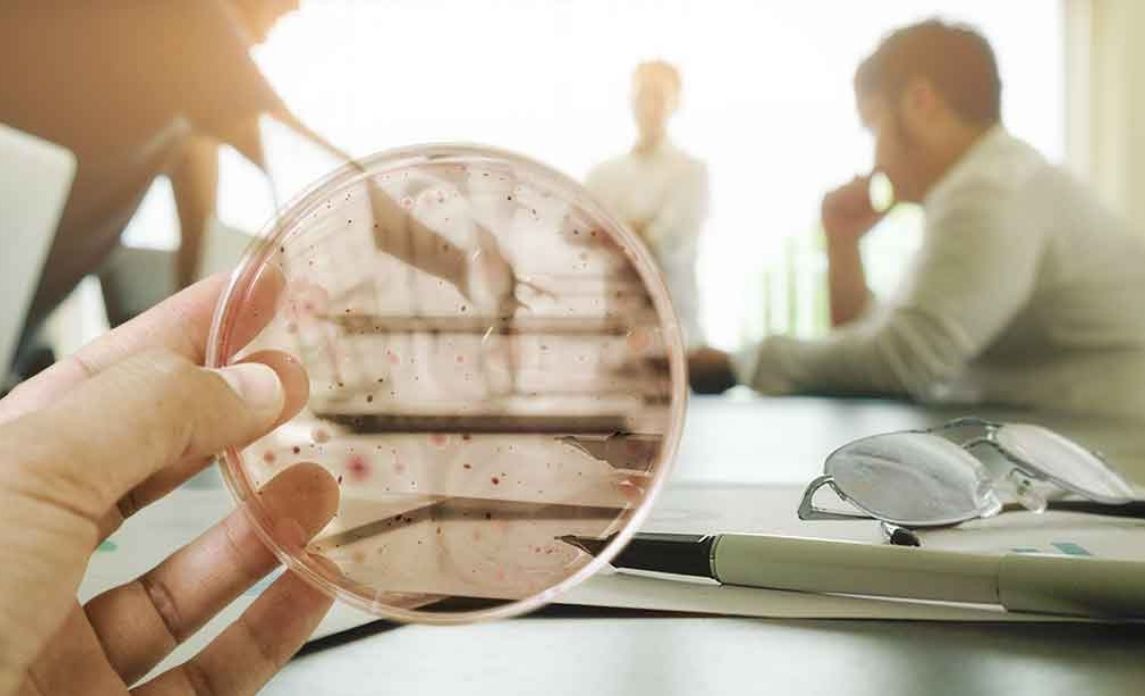
Bacteria in commercial spaces magnified

Commercial spaces are large, full of people, and contain a lot of shared and common spaces. Regardless of the type of space, be it a restaurant of café, school, or office – commercial areas naturally gather and harbour significant amounts of bacteria that need to be killed by cleaning solutions.
Many of these bacteria are harmless, but unfortunately, some can be harmful to human health. For this reason, it is a good idea to sanitise and clean these spaces regularly or contract a commercial cleaning company to manage it for you.
The following are some of the common bacteria found in various commercial spaces:
Restaurants
Commercial kitchens such as those in cafés and restaurants are high-risk areas for hazardous germs. Any kitchen can spread food-borne illnesses that are bad for the human body, but kitchens providing food for the public carry much greater risk. This is also why dining establishments require specific cleaning requirements.
Salmonella can take from 12 – 72 hours to cause symptoms after exposure and causes fever, stomach cramps, headaches, and diarrhoea. While very rare, severe salmonella poisoning can also cause Typhoid fever. It is spread through contaminated meats, seafood, milk, and eggs.
Salmonella can even contaminate fruits and vegetables if they have been in contact with manure in the soil and not washed properly. It is one of the most common causes of food poisoning.
Campylobacter is the leading cause of food poisoning and is spread through undercooked meats (especially chicken), untreated water and unpasteurised milk. It can take several days for symptoms to start after infection, and will most likely present as vomiting and diarrhoea. It can leave permanent health issues even after the infection has gone, including bowel and nerve conditions.
Listeria is spread through contaminated raw foods and water. It is destroyed by cooking temperatures of 75 degrees Celsius or higher, but can still be transferred through cheeses, raw eggs, shellfish, or deli meats and sandwiches. It is not as commonly contracted as salmonella or campylobacter, but it is especially dangerous for pregnant people, the elderly, or people with low immunity or weaker immune systems. It can cause fever and headaches, blood poisoning, meningitis, and miscarriages or foetal harm in pregnant people.


Offices
Office surfaces and computer equipment are some of the most germ-ridden places that you will come into contact with. Research carried out by Hloom found some pretty astonishing statistics, including that there are 34 times more bacteria on a coffee pot handle than there is on a toilet seat!
E. Coli (Escherichia coli) is spread through offices by poor hygiene – mainly people who don’t wash their hands after using the bathroom. It is commonly found on computer keyboards, taps, and door handles. E. Coli causes abdominal cramping, fever, vomiting and diarrhoea. If it is present in food preparation or kitchenette areas it can also lead to food poisoning.
Staph lives in our respiratory tract and on our skin, and is most commonly transferred onto surfaces by skin contact or not covering the mouth or nose when you sneeze. Staph causes skin infections that can look like large pimples or boils, pneumonia, endocarditis, bone infections, and toxic shock syndrome.
Norovirus is spread through contaminated food and water and is easily picked up from objects and surfaces. The bacteria can survive on surfaces for days or even weeks after contamination. It causes vomiting, diarrhoea, muscle pains, and abdominal pain.
Schools
Dangerous bacteria can spread easily and quickly through schools and day-care centres if surfaces and equipment are not properly sanitised and maintained. Viral and bacterial outbreaks can be especially harmful to young children and so extra care should be taken to ensure hygiene in schools.
Staph (detailed above) is also common in schools and can be the cause of contagious skin infections among students. As some strains of staph are resistant to antibiotics, it’s especially important to sanitise surfaces to prevent the spread of these bacteria. It can also cause conjunctivitis.
Coxsackievirus, better known as hand, foot and mouth disease, is most often seen in younger children. It presents as blisters on the hands and feet and in the mouth, and can also include fever and a sore throat. It is highly contagious and most common in the warmer months.
Strep (streptococcus pyogenes) most commonly presents in schools as strep throat and is highly contagious. It is an infection of the tonsils and throat and causes sore throats, fever, chills, and swollen lymph nodes. It requires antibiotics to treat it. If left untreated, it can lead to serious kidney and heart complications.
Streptococcus pneumonia, while a lot less common, can also be found in schools and is particularly harmful bacteria. It can cause ear infections, pneumonia, bronchitis, blood poisoning, and meningitis.

Keeping your spaces free from bacteria every day
No matter what the challenge, Crewcare is here to help! We can take care of one-off or regular commercial cleaning jobs for offices, restaurants, cafés, and schools and early learning centres. You can trust our security-vetted and highly trained staff to manage and care for your property with our environmentally friendly yet highly effective cleaning practices and cleaning products.